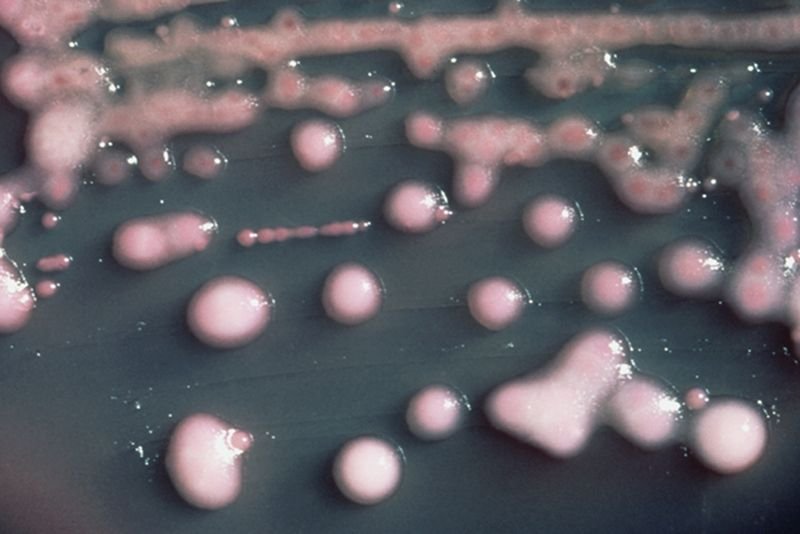
Kolonia bakterii Klebsiella pneumoniae. To właśnie jeden z jej szczepów okazał się być odporny na wszystkie znane rodzaje antybiotyków.

W tym samym czasie, gdy Europejczycy obchodzili kolejny już Dzień Wiedzy o Antybiotykach, opinia publiczna w Nowej Zelandii usłyszała o szczepie bakterii Klebsiella pneumoniae, który jest zupełnie odporny na wszystkie dostępne medycynie antybiotyki. Ujawniono, że zarażony nią mężczyzna zmarł w jednym z tamtejszych szpitali. To kolejny sygnał, że wkraczamy w “epokę postantybiotykową”. Lekarze mówią o zniweczeniu dziesiątek lat osiągnięć medycyny.
Prof. Andrzej Gładysz, były Krajowy Konsultant ds. Chorób Zakaźnych, przyznaje w rozmowie z naTemat, że odporność drobnoustrojów na antybiotyki nie jest żadną nowością, ani szczególnym zaskoczeniem.
Podnosimy ten temat od lat. Okazuje się, że bakterie w zaskakująco inteligentny sposób starają się bronić przed antybiotykami, wytwarzając kolejne enzymy ochronne. Trzeba to powiedzieć jasno: trudno liczyć, że uda się nam stworzyć środek, który byłby skuteczny w każdym przypadku.
Co więcej, jak pokazuje przykład Briana Poola, medycyna powoli zaczyna przegrywać walkę z drobnoustrojami. Dlaczego tak się dzieje? Dlaczego antybiotyki są coraz mniej skuteczne? Przede wszystkim dlatego, że się ich nadużywa. Stale poddawane ich działaniu bakterie mają szansę adaptować się i stają się coraz bardziej odporne.
Problem jest na tyle poważny, że mówi się, iż świat z wolna wkracza w erę postantybiotykową. Jak pisze Maryn McKenna, autorka książki “Superbug”, musimy sobie bowiem zdawać sprawę, że konsekwencje zachodzących zmian będą znacznie poważniejsze, niż się na pierwszy rzut oka wydaje.
– Świat bez antybiotyków jest coraz bardziej realny, bo one przestają działać – mówiła w Polskim Radiu prof. Waleria Hryniewicz, lekarz mikrobiolog, przewodnicząca Narodowego Programu Ochrony Antybiotyków i Konsultant Krajowy w dziedzinie Mikrobiologii Lekarskiej. Ona również podkreślała, że powinniśmy ograniczyć przyjmowanie antybiotyków. – Stosujemy je za często, na wszelki wypadek i stosujemy je źle – mówiła.

